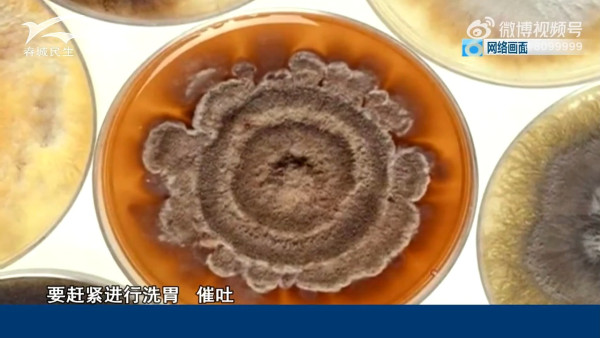
深圳夜市黑幕|路邊攤收檔食材變「老鼠自助餐」? 超噁心相片曝光 內媒揭3大衛生隱憂

自深圳修訂條例放寬地攤限制後,夜間流動攤販數量激增。有內地媒體深入觀察深圳城中村內停放的餐車狀況,發現不少攤車在深夜「收工」後,食材和餐具裸露在外,衛生堪憂,更存在煤氣罐等安全隱患。部分攤販雖堅持清潔,但整體亂象令人質疑地攤食物的品質與監管,即看下文了解更多。
深圳自2023年9月修訂《市容和環境衛生管理條例》,明確「不再全面禁止路邊攤」後,地攤經濟迅速復甦,尤以深夜時段(下午6時至凌晨2時)的夜攤數量更呈倍數增長。近年港人北上消費成風,當中有部分港人更會購買「地攤美食」,不過有內地媒體曾揭發其衛生情況惡劣,
收攤餐車的三大衛生隱憂
記者隨機觀察了三個城中村共60輛餐車,發現許多攤販的生活作息是日夜顛倒,而餐車在深夜「下班」後的衛生情況令人擔憂。
雖然大部分仍在營業的餐車會用防水布包裹,但「半包」餐車仍佔多數。在城中村環境中,部分餐車被發現敞開堆放未經嚴密包裝的一次性餐盒、塑料袋及鐵質餐具。這些物品裸露在外,極易受到老鼠、蟑螂等害蟲的污染。
更有甚者,有燒烤攤直接將生肉、蔬菜等食材,以及可循環使用的鐵串串,存放在攤車中的「櫃子」內過夜,未上鎖且無人看管。有居民坦言,目睹此景後已決定不再光顧地攤,認為缺乏監管下的食材衛生全憑攤主「良心」。
另外,鑑於許多攤車經營油炸、煎炒類食物,車上往往掛有一至兩個煤氣罐。這些煤氣罐在公共空間內長期裸露停放,一旦遇上高溫暴曬、兒童玩火或車輛碰撞等不可控因素,將構成重大的公共安全隱患。
廢棄攤車佔道礙市容
報導亦有指出,除了營業中的餐車,被閒置廢棄的攤車亦是城中村的另一問題。這些佈滿灰塵、收款二維碼被遮擋的廢棄攤車,通常是創業失敗的結果。
然而,這些「失敗的實驗品」並未被及時清理回收,反而長期霸佔狹窄的街道和人行道等公共空間。部分廢棄餐車更淪為「廣告垃圾車」,車上堆滿垃圾、佈滿油漬,嚴重影響市容,加劇了本已緊張的城市空間問題。
亦有部分攤主良心經營積累口碑
儘管亂象叢生,部分攤主仍堅持高標準的衛生管理。一對賣涼皮涼面的老夫婦每天堅持徹底清洗餐車,一位賣甘蔗汁的大叔亦每日清理榨汁機上的高糖污垢,避免招惹老鼠。這位大叔憑藉乾淨的出品積累大量回頭客,每日營業額可達600元人民幣。
來源:深圳微時光
內地街頭不乏賣甘蔗汁的小販,許多人都會買來消暑解渴。然而,近日「你喝到的甘蔗汁可能是糖精水」的話題衝上微博熱搜,揭露街頭甘蔗汁的重重黑幕。
內地街頭甘蔗汁切勿亂飲!
內地街頭不少售賣新鮮甘蔗汁的攤檔,看似樸實,實則全是陷阱。原來,為了提高出汁率,部分不良商家會將榨汁機進行改裝,加裝兩個開關。一個開關用來控制榨汁,另一個則控制水泵,從隱藏的水箱中抽水。當商家同時按下兩個開關,水箱中渾濁且略帶黃色的不明液體,就會被微型水泵抽入榨汁機,與甘蔗汁混合在一起。
原本一根甘蔗只能榨出一瓶汁,這樣一來卻能榨出四、五瓶甚至更多。更甚的是,這些不明液體的來源不明,甚至可能來自裝有死蟲的泡沫箱,嚴重污染了飲品,讓消費者喝到的不再是純正甘蔗汁,而是被污染的「糖精混合液」。
除了摻水問題,甘蔗汁的衛生環境也極其惡劣。由於甘蔗榨汁機難以拆開清洗,榨汁後的殘渣會殘留在刀片、濾網和機身內部。如果長時間不清理,這些殘渣就會成為大腸桿菌和霉菌的溫床。大腸桿菌可能導致腹瀉、嘔吐等症狀,而霉菌則可能含有毒素,對人體健康有害。
此外,甘蔗本身的品質也可能存在問題。與橙子、桃子等發霉肉眼可見的水果不同,甘蔗一旦發霉,外表可能看起來仍很新鮮,但內部已變成「紅芯」。這種霉變的甘蔗會產生一種名為「β-硝基丙酸」的神經毒素。即使將發霉部分砍掉,毒素的菌絲仍會延伸到其他部分,因此一點紅芯甘蔗都不能吃。過去,曾有內地民眾因誤食霉變甘蔗而導致多器官衰竭,甚至死亡。
因此,如果想喝甘蔗汁,務必擦亮眼睛,選擇正規、衛生的攤位,或者直接購買整根甘蔗回家自行處理,才能喝得更安心。
來源:微博
UTravel熱門旅遊話題
贏走題樂園門票、酒店Staycation及人氣產品
↓立即登記參加!賺取無上限現金賞💰↓